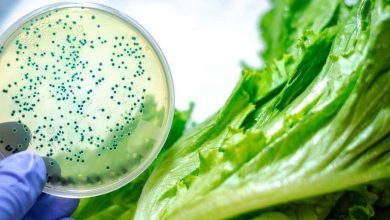

Paciente con cáncer: ¡Aliméntate de manera sana y vence la enfermedad!

El diagnóstico suele ser uno de los momentos más complejos de los pacientes con cualquier tipo de cáncer. Sin embargo, adaptar los estilos de vida también suele ser algo difícil para ellos, por lo que hoy traemos algunas recomendaciones nutricionales para pacientes oncológicos.
Antes de leerlas, te daremos tips generales que debes consultar primero con un especialista que te dirá cuál es la mejor opción alimenticia para el tipo de cáncer que padeces. ¡Empecemos!
De acuerdo con los Institutos Nacionales de Salud (NIH, por sus siglas en inglés), los pacientes con cáncer necesitan una dieta especial y una nutrición adecuada dado que les permite “mantener un peso saludable, conservar la fuerza, mantener sanos los tejidos corporales y disminuir los efectos secundarios durante y después del tratamiento”.
Tips
Por esa razón, la literatura médica-científica ha emitido algunos consejos nutricionales para quienes reciben la noticia de que alojan células cancerosas en sus organismos. De acuerdo con el portal médico MayoClinic, algunas de ellas son:
- Evitar la carne al carbón y no ingerir proteínas rojas constantemente
- Consumir en mayor medida frutas, verduras y granos enteros
- El brócoli es uno de los vegetales por excelencia para la dieta del cáncer
- Es mejor evitar las bebidas alcohólicas
- Incrementa el consumo de pescado y ácidos omega-3 que encuentras en las nueces, la linaza y demás
- Reduce la ingesta de carnes procesadas, ahumadas, curadas con nitrito y alimentos preservados con sal
Beneficios de alimentarse bien durante el cáncer
Según la American Cancer Society, llevar una buena dieta durante la quimioterapia y los demás procesos que tienen que ver con el cáncer le permitirá al paciente no solo tener más fuerzas para los posibles efectos secundarios, sino también mejorar su estado anímico.
“Una alimentación saludable también puede evitar que el tejido corporal se rompa y se produzcan nuevos tejidos. Las personas que se alimentan bien pueden tolerar mejor los efectos secundarios del tratamiento”, expresa la entidad.
Igualmente, exhortan a mejorar la alimentación debido a que, se ha demostrado, que los pacientes mejor alimentados podrían tener mejores resultados con los tratamientos a los que se someten.
Algunas de las recomendaciones adicionales que dejan tienen que ver con probar nuevas opciones alimenticias que brinden vitaminas y otros nutrientes, evitar los alimentos que sean muy salados, ahumados y en escabeche e incrementar el consumo de alimentos vegetales coloridos (tanto frutas como verduras) que contienen sustancias naturales que fomentan la salud.
Referencias: INH, American Cancer Society, MayoClinic.